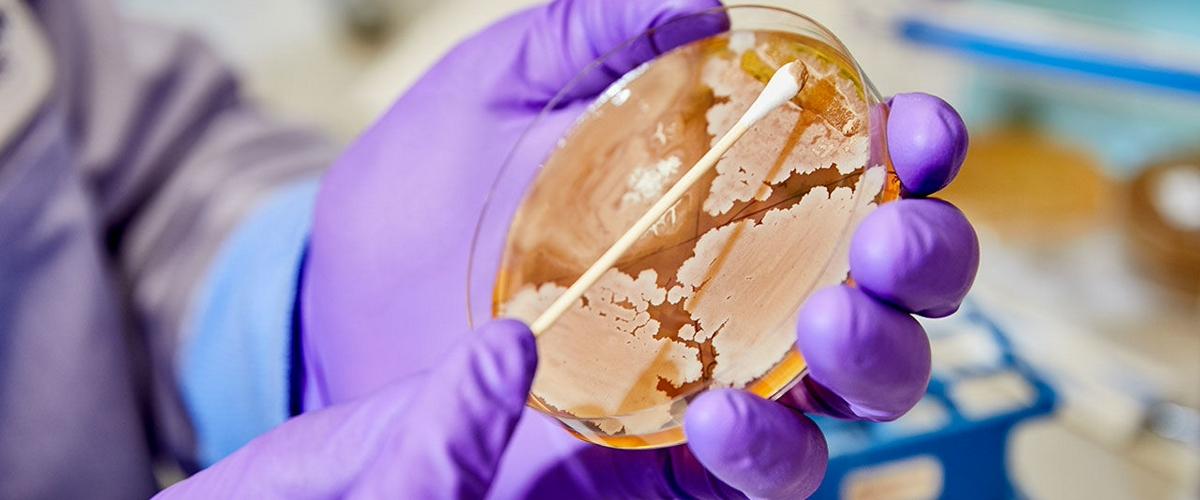
TODO:

В мире почти 850 млн человек страдают хроническими заболеваниями печени, которые со временем могут приводить к циррозу и раку. Сегодня для диагностики наиболее распространенного заболевания печени — неалкогольной жировой болезни — применяется МРТ и биопсия, однако оба метода имеют свои недостатки. Инвазивная биопсия может повредить здоровые участки органа, а доступ к магнитно-резонансной томографии ограничен для пациентов из удаленных регионов.
Американские ученые разработали более простой и дешевый способ оценить состояние печени. Новый тест анализирует образцы стула пациентов, которые содержат уникальные биомаркеры. Работа опубликована на сайте Института биологических исследований Солка.
«Микробиота кишечника является динамическим показателем незначительных изменений в состоянии здоровья и обеспечивает точное понимание работы организма. Мы стремились разработать универсальный тест на фиброз и цирроз печени на основе особых биомаркеров микробиоты», — прокомментировал соавтор исследования Рональд Эванс.
Для идентификации наиболее информативных биомаркеров ученые применили ИИ и определили 19 видов бактерий, характеризующих состояние печени.
Тест с точностью 94% мог определять наличие цирроза печени и стадию болезни, показали эксперименты.
«Этот простой и широко доступный инструмент может стать настоящим переломным моментом в диагностике», — заключил Эванс.
В настоящий момент ученые намерены выяснить, влияет ли корректировка состава микробиоты кишечника на замедление заболеваний печени. Они также планируют разработать тесты для рака кишечника, болезни Альцгеймера и других заболеваний, при которых регуляция микробиоты нарушается.
Другая группа исследователей выяснила, что по составу микроорганизмов можно определить возраст человека. По биомаркерам на коже его можно назвать с точностью до 4 лет.